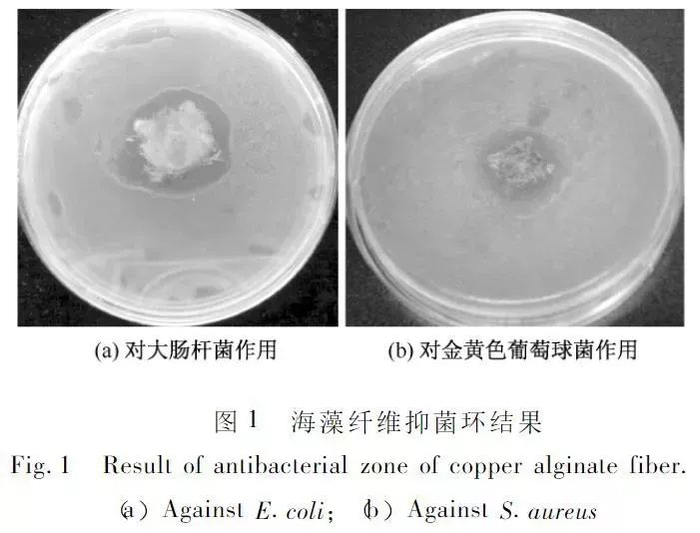

↓↓↓
新疆长绒棉因纤维较长而得名
起各项质量指标都远超国家规定标准
可以说是棉花中的贵族棉

长绒棉只有在新疆全年日照超过3000小时的环境中才能生长
采摘起来也是非常讲究,必须使用人工采摘
并且采摘期集中在9-10月棉花盛开最旺盛的时候采摘
采摘期最长不能超过40天

独特的生长环境,和昂贵的采摘成本
让新疆长绒棉被誉为“白色黄金”
还没采摘就已经被预定了,一花难求

用它做出来的袜子弹性好、亲肤舒适
透气性强,吸湿效果好、还能防止细菌滋生

棉花产地:新疆阿克苏棉花种植场
棉花供应公司:哈密康泰纺织有限责任公司

No.1
纯棉面料,吸汗舒适
长绒棉虽然好但也不是越多越好
只有经过科学配比才能制作出最舒适好穿的袜子
70%的新疆长绒棉、保证了袜子的舒适性和透气性
20%的氨纶让袜子弹性更大,更加贴合脚面
10%的抑菌纤维,让脚部无法滋生细菌
给脚部一个干净无菌的环境

有了这样的黄金比例搭配
袜子才能同时具有吸湿排汗、柔软舒适、长效抑菌特点
容易出脚汗的朋友穿上它
脚部一整天都干爽舒适、运动一天脚一点也不臭
保暖防臭海藻袜
优惠价:49元/盒(6双)
2盒立减10元,仅需88元(12双)
No.2
匠心工艺 特殊设计
我们平时穿的袜子在袜头部位很容易硌脚
穿一天下来,脚疼的不行

这款袜子采用先进的双针缝制和超薄缝合技术
袜头Y字走线更加贴合脚面,没有一丝凸起感
穿到脚上没有一丝不适感

拥有优良的螺纹工艺,加大了袜子的摩擦力
冬天穿着袜子踩在地板上,一点不怕脚底打滑
保暖防臭海藻袜
优惠价:49元/盒(6双)
2盒立减10元,仅需88元(12双)
↓↓↓
No.3
非药剂浸泡,海藻纤维天然抗菌99%
一双能抑菌的袜子
就能很大程度上解决脚异味、脚痒的麻烦
经过多年研究,终于发现了不怕洗的抗菌剂——海藻
海藻中富含铜、银、锌、矿化等抗菌离子
对大肠杆菌、黄色葡萄球菌的抑菌效果都非常好
持久、高效抗菌的同时,又保证天然无害

科研人员在实验环境下的测试结果显示:
菌落周围出现了明显的抑菌环
它们能破坏细菌膜壁和细菌合成蛋白酶活性
使细菌失去分裂增殖的能力而死亡
达到抑菌抗菌的效果

面料以棉为主料,加入抗菌天然海藻纤维
不仅抗菌,还能吸收脚部皮肤所产生的湿气!

更重要的是,作为来自大自然的纤维
它的亲肤程度是人工纤维不能比的。
小编查了查他们的检查报告
发现金黄色葡萄球菌的抗菌率达到了99%

吸湿性好,滑爽,穿着舒适
易洗易干,防臭,吸汗排湿。
保暖防臭海藻袜
优惠价:49元/盒(6双)
2盒立减10元,仅需88元(12双)
↓↓↓
这样含量高的纯棉袜
再水洗后,弹性会更好
柔软度更佳,袜子更紧密
不但好穿,颜值也非常高

袜子分男女两款
男袜38—43码,女袜35—40码
无论是胖脚还是瘦脚都能穿

6双袜子 6种颜色
每天都是不一样的颜色
可以根据平日穿着来搭配

保暖防臭海藻袜
优惠价:49元/盒(6双)
2盒立减10元,仅需88元(12双)



